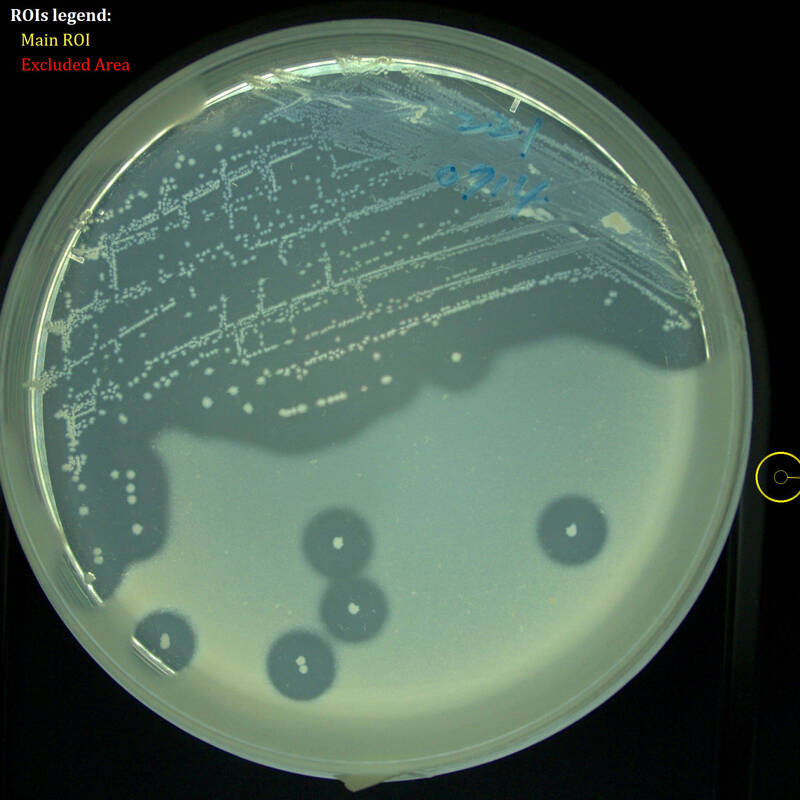

蛋雞場惡臭救星!畜試所研發益生菌降近4成臭味、讓母雞多生蛋
2025/04/29 12:52 記者楊媛婷/台北報導
蛋雞場因常散發惡臭,屬於鄰避設施。(資料照)
蛋雞場若缺乏管理,會有惡臭擾鄰,甚至引發周邊居民包抗議,農業部畜產試驗所研發適合蛋雞飼養使用的益生菌枯草芽孢桿菌TLRI 221」(Bacillus subtilis TLRI 221),可有效減少雞糞臭味,降低雞糞主要臭味來源的氨氣濃度37%與硫化氫濃度39%,還能提升5%雞蛋產量。
不少人遠遠就能聞到蛋雞場的惡臭味,因此被列為鄰避設施,新設蛋雞場也難以申請取得牧場登記,為改善蛋雞場惡臭問題,畜試所研發適合於蛋雞飼養使用的益生菌,在蛋雞飼糧中添加枯草芽孢桿菌TLRI 221益生菌,可降低糞便臭味、提升生產效率及雞蛋品質,還能減少治療用抗生素的使用,解決蛋雞場日常工作會遭遇到的問題。
畜試所進一步說明,透過12週的蛋雞飼養試驗,經氣體檢測證實,使用該益生菌可降低蛋雞糞便中37%氨氣濃度及39%硫化氫濃度,有效減少臭味,同時提升5%產蛋量及改善4%飼料換蛋率,降低蛋雞小腸內病原性大腸桿菌及革蘭氏陰性菌數量,提升枯草芽孢桿菌(益生菌)含量。
不僅降低臭味,提升產蛋效率,畜試所指出,飼料添加枯草芽孢桿菌TLRI 221後,雞蛋品質還能延緩劣化,經5週常溫儲存仍維持較好的雞蛋品質,且添加此菌的雞蛋經品評試驗,亦獲得較佳的口感及消費者接受度。
畜試所副研究員施柏齡指出,枯草芽孢桿菌TLRI 221除可用在蛋雞外,也可用於豬隻,同樣也可降低豬隻糞便的臭味,另枯草芽孢桿菌TLRI 221具備耐高溫特性,並擁有特定消化酵素活性,經多項科學評估,包括胞外酵素活性、耐酸耐膽鹽性、細胞毒性及細胞黏附性等指標,符合飼料管理法規中益生菌使用規範,具備作為蛋雞飼料添加物的應用潛力,未來將商品化,並推廣業者使用,目前已有一家飼料業者技轉。
TLRI 221菌株分解蛋白質能力強,可有效降低雞糞臭味。(畜試所提供)




















